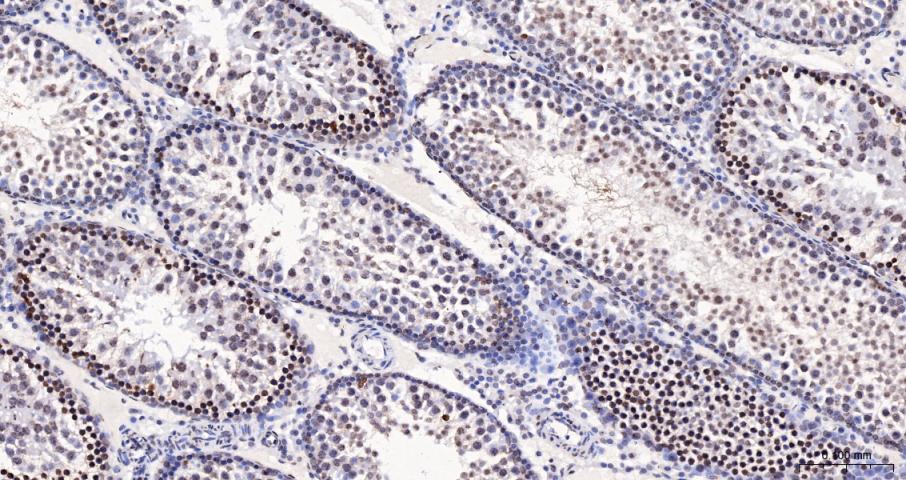
Histone H3(di methyl K27) Mous
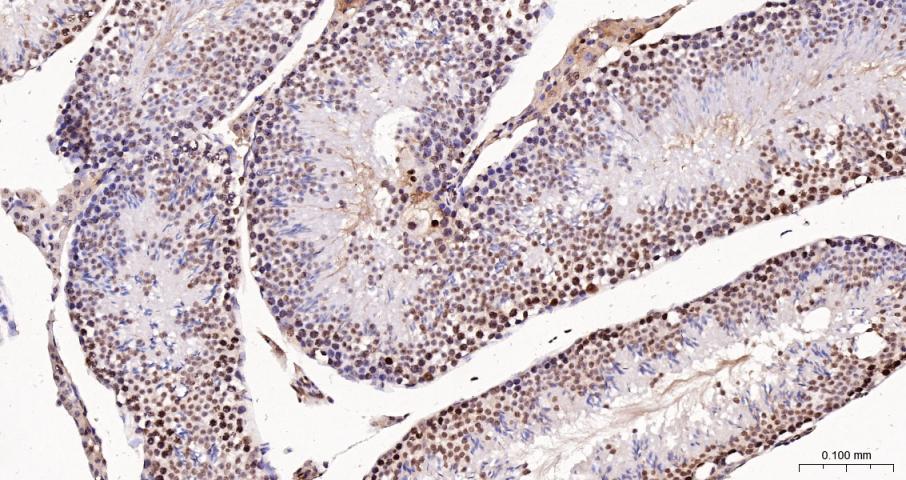
Histone H3(di methyl K27) Mous

相关产品推荐更多 >

MT2A Rabbit pAb, PerCP-Cy7 conjugated(bs-1328R-PerCP-Cy7)-100ul
¥2980
beta I Tubulin Mouse mAb, BF405 conjugated(bsm-33041M-BF405)-100ul
¥2980
RAF1 Rabbit pAb, PerCP-Cy5.5 conjugated(bs-23171R-PerCP-Cy5.5)-100ul
¥2980
Puratrophin 1 Rabbit pAb(bs-11747R)-50ul/100ul/200ul
¥1180
TENT5A Rabbit pAb(bs-14995R)-50ul/100ul/200ul
¥1180
万千商家帮你免费找货
0 人在求购买到急需产品
- 详细信息
- 文献和实验
- 技术资料
- 应用范围:
产品信息以Bioss网站为准
- 规格:
50ul/100ul/200ul/200ug
| 规格: | 50ul | 产品价格: | ¥1180.0 |
|---|---|---|---|
| 规格: | 100ul | 产品价格: | ¥1980.0 |
| 规格: | 200ul | 产品价格: | ¥2800.0 |
| 规格: | 200ug | 产品价格: | ¥5600.0 |
| 产品编号 | bsm-33107M |
| 英文名称 | Histone H3(di methyl K27) Mouse mAb |
| 中文名称 | 甲基化组蛋白H3(di methyl K27)单克隆抗体 |
| 英文别名 | Histone H3(di methyl Lys27); H3K27me2; H3 histone family member E pseudogene; H3 histone family, member A; H3/A; H31_HUMAN; H3F3; H3FA; Hist1h3a; HIST1H3B; HIST1H3C; HIST1H3D; HIST1H3E; HIST1H3F; HIST1H3G; HIST1H3H; HIST1H3I; HIST1H3J; HIST3H3; histone 1, H3a; Histone cluster 1, H3a; Histone H3 3 pseudogene; Histone H3.1; Histone H3/a; Histone H3/b; Histone H3/c; Histone H3/d; Histone H3/f; Histone H3/h; Histone H3/i; Histone H3/j; Histone H3/k; Histone H3/l; H3.1; H3/d; H3C1; H3C10; H3C11; H3C12; H3C2; H3C3; H3C4; H3C7; H3C8; H3FD; |
| 产品应用 | WB=1:500-2000, IHC-P=1:100-500, IHC-F=1:100-500, IF=1:100-500 Not yet tested in other applications. |
| 交叉反应 | Human, Mouse, Rat |
| 抗体来源 | Mouse |
| 免疫原 | KLH conjugated synthesised methylpeptide derived from human Histone H3 around the methylation site of di methyl K27 |
| 亚型 | IgG1 |
| 性状 | Liquid |
| 纯化方法 | affinity purified by Protein G |
| 克隆类型 | Monoclonal |
| 理论分子量 | 15 kDa |
| 浓度 | 1mg/ml |
| 储存液 | 0.01M TBS (pH7.4) with 1% BSA, 0.02% Proclin300 and 50% Glycerol. |
| 研究领域 | Epigenetics and Nuclear Signaling > ChIP assays > ChIP antibodies Epigenetics and Nuclear Signaling > Histones > H3 > Methylated |
| 亚基 | The nucleosome is a histone octamer containing two molecules each of H2A, H2B, H3 and H4 assembled in one H3-H4 heterotetramer and two H2A-H2B heterodimers. The octamer wraps approximately 147 bp of DNA. Interacts with GCN5, whereby H3S10ph increases histone-protein interactions. Interacts with PDD1 and PDD3. |
| 亚细胞定位 | Nucleus. Chromosome. Note=Localizes to both the large, transcriptionally active, somatic macronucleus (MAC) and the small, transcriptionally inert, germ line micronucleus (MIC). |
| 组织特异性 | Expressed in testicular cells.Expressed during S phase, then expression strongly decreases as cell division slows down during the process of differentiation. |
| 翻译后修饰 | Phosphorylated to form H3S10ph. H3S10ph promotes subsequent H3K14ac formation by GCN5. H3S10ph is only found in the mitotically dividing MIC, but not in the amitotically dividing MAC. H3S10ph is correlated with chromosome condensation during mitotic or meiotic micronuclear divisions.
Acetylation of histone H3 leads to transcriptional activation. H3K14ac formation by GCN5 is promoted by H3S10ph. H3K9acK14ac is the preferred acetylated form of newly synthesized H3. Acetylation occurs almost exclusively in the MAC. Methylated to form H3K4me. H3K4me is only found in the transcriptionally active MAC. Methylated to form H3K9me in developing MACs during conjugation, when genome-wide DNA elimination occurs. At this stage, H3K9me specifically occurs on DNA sequences being eliminated (IES), probably targeted by small scan RNAs (scnRNAs) bound to IES, and is required for efficient IES elimination. H3K9me is required for the interaction with the chromodomains of PDD1 and PDD3. The full-length protein H3S (slow migrating) is converted to H3F (fast migrating) by proteolytic removal of the first 6 residues. H3F is unique to MIC, and processing seems to occur regularly each generation at a specific point in the cell cycle. |
| 相似性 | Belongs to the histone H3 family. |
| 功能 | Core component of nucleosome. Nucleosomes wrap and compact DNA into chromatin, limiting DNA accessibility to the cellular machineries which require DNA as a template. Histones thereby play a central role in transcription regulation, DNA repair, DNA replication and chromosomal stability. DNA accessibility is regulated via a complex set of post-translational modifications of histones, also called histone code, and nucleosome remodeling. H3 is deposited into chromatin exclusively through a DNA replication-coupled pathway that can be associated with either DNA duplication or DNA repair synthesis during meiotic homologous recombination. |
| 保存条件 | Shipped at 4℃. Store at -20℃ for one year. Avoid repeated freeze/thaw cycles. |
| 注意事项 | This product as supplied is intended for research use only, not for use in human, therapeutic or diagnostic applications. |
| 背景资料 | Modulation of the chromatin structure plays an important role in the regulation of transcription in eukaryotes. The nucleosome, made up of four core histone proteins (H2A, H2B, H3 and H4), is the primary building block of chromatin. The N-terminal tail of core histones undergoes different posttranslational modifications including acetylation, phosphorylation and methylation. These modifications occur in response to cell signal stimuli and have a direct effect on gene expression. In most species, the histone H2B is primarily acetylated at lysines 5, 12, 15 and 20. Histone H3 is primarily acetylated at lysines 9, 14, 18 and 23. Acetylation at lysine 9 appears to have a dominant role in histone deposition and chromatin assembly in some organisms. Phosphorylation at Ser10 of histone H3 is tightly correlated with chromosome condensation during both mitosis and meiosis. |
| 应用 | 推荐稀释比例 |
| {WB} | {1:500-2000} |
| {IHC-P} | {1:100-500} |
| {IHC-F} | {1:100-500} |
| {IF} | {1:100-500} |

风险提示:丁香通仅作为第三方平台,为商家信息发布提供平台空间。用户咨询产品时请注意保护个人信息及财产安全,合理判断,谨慎选购商品,商家和用户对交易行为负责。对于医疗器械类产品,请先查证核实企业经营资质和医疗器械产品注册证情况。
文献和实验[IF={{ 3.5 }}] {Di Wu. et al. Discovery of novel pyridone-benzamide derivatives possessing a 1-methyl-2-benzimidazolinone moiety as potent EZH2 inhibitors for the treatment of B-cell lymphomas. BIOORGAN MED CHEM. 2024 Apr;:117725} {WB} {Human}
Identifying Differential Histone Modification Sites from ChIPseq Data
a hidden Markov model (HMM) to infer the states of histone modification changes at each genomic location. We evaluated the performance of ChIPDiff by comparing the H3K27me3 modification sites between mouse embryonic stem cell (ESC) and neural progenitor
upon the dual pulldown to incorporate a third pulldown which is an iteration of the ChIP and is a pulldown for H3K27me3+ (Figure 1b). The third assay described here is the biotin-RNA pulldown of a low-copy RNA that spans the siRNA targeted promoter region
Isolation of CpG Islands Using a Methyl-CpG Binding Column
. 1 and 2 for reviews). In addition to distinctive DNA characteristics, CpG islands also have an open chromatin structure in that they are hyperacetylated, lack histone H1, and have a nucleosome-free region (3) . The major reason for interest in CpG islands
技术资料暂无技术资料 索取技术资料






